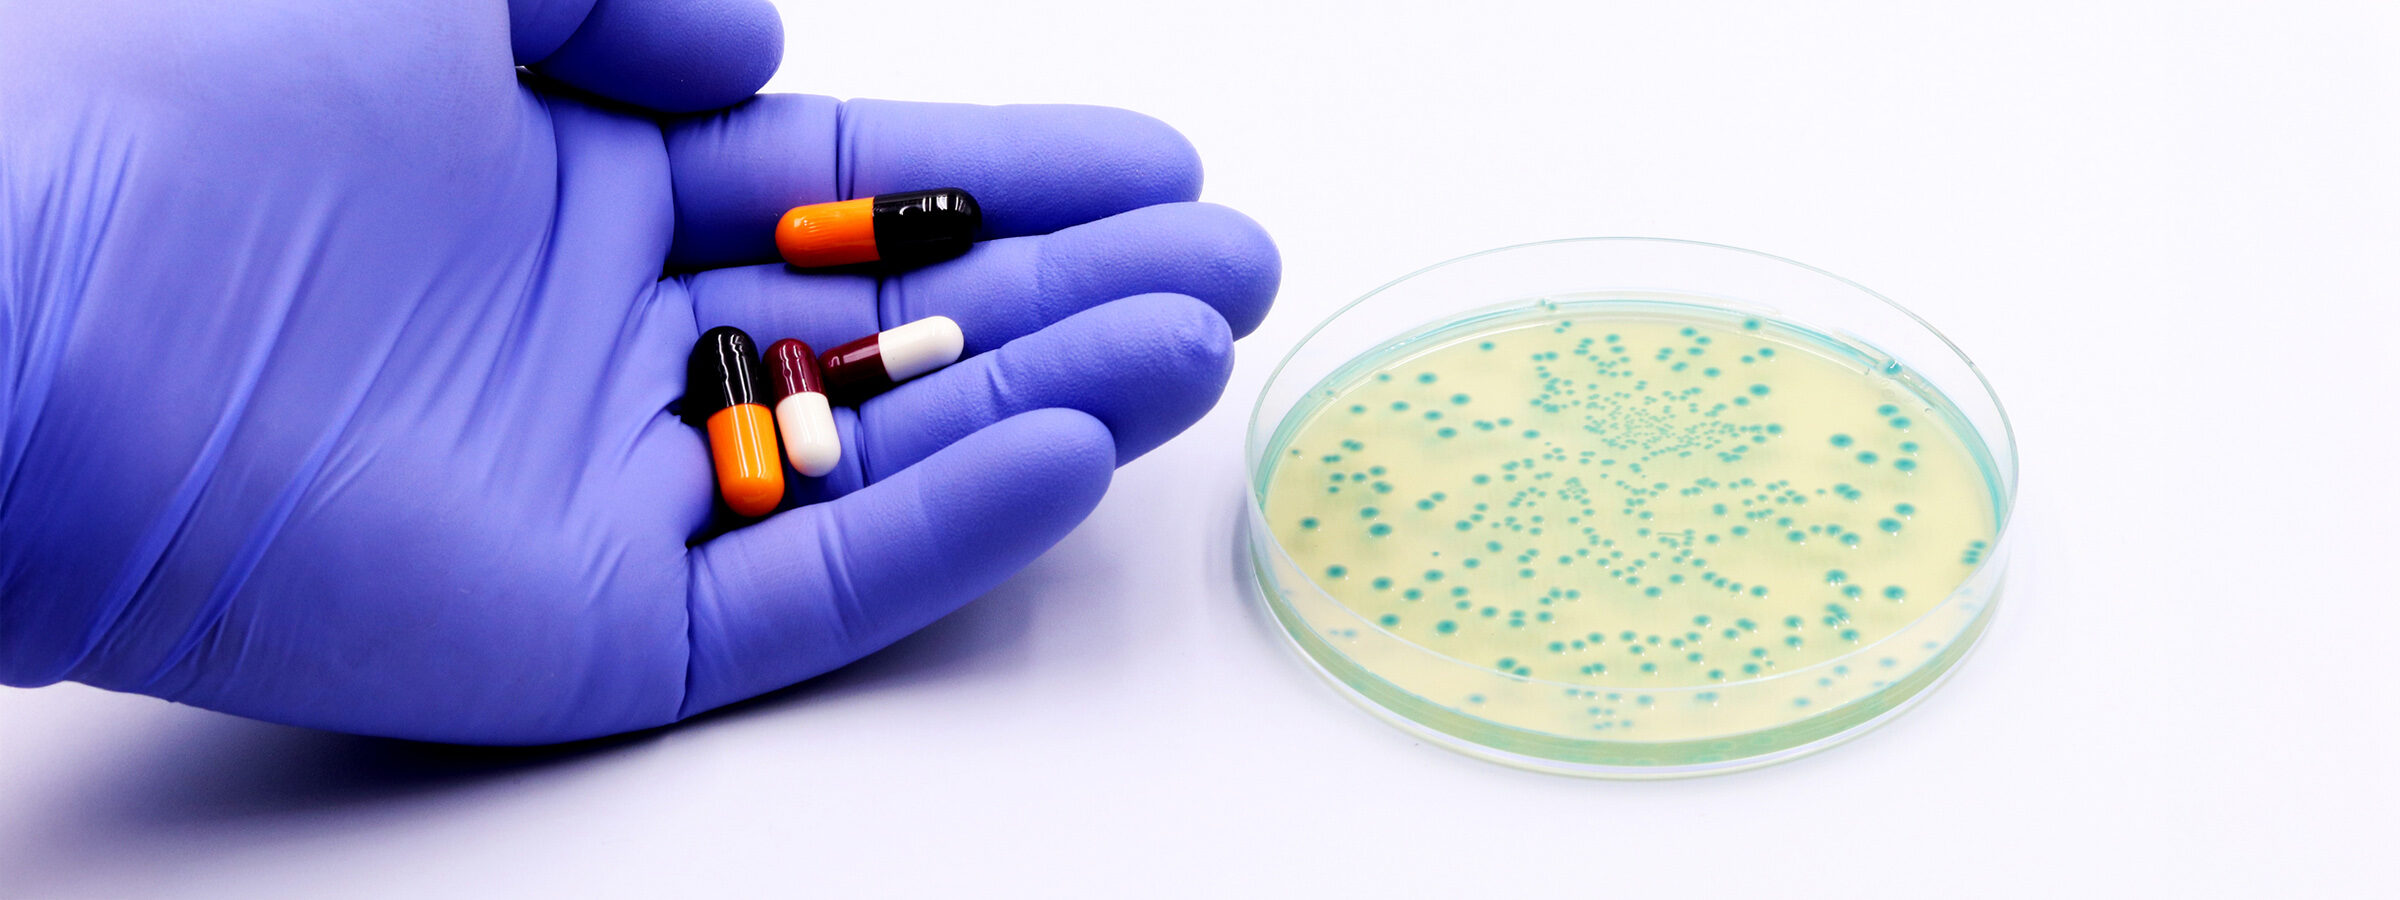

Gli antibiotici sono sostanze spesso impiegate per la prevenzione e il trattamento di infezioni. Tuttavia, a seguito dell’uso smisurato e inappropriato, oggi sempre più batteri stanno sviluppando una resistenza agli antibiotici. Gli scienziati osservano il fenomeno con una certa apprensione.
Tra tutte le scoperte del 20° secolo, gli antibiotici sono quelli che hanno portato i maggiori cambiamenti in campo medico nonché ridotto la mortalità, consentendo di curare malattie infettive persistenti come la polmonite o la miocardite batterica.
Un antibiotico è in grado di interrompere il processo di divisione cellulare dell’agente patogeno responsabile di un’infezione e ne impedisce la proliferazione. Sebbene le malattie infettive in questione non siano state debellate, grazie agli antibiotici sono per lo più curabili. Gli antibiotici possono avere effetti collaterali, tra cui i più frequenti sono allergie, ripercussioni sulla flora intestinale o vaginale che a loro volta possono essere causa di dissenteria o micosi nelle zone intime.
Gli antibiotici andrebbero assunti per tutto il periodo prescritto dal medico. La scomparsa prematura dei sintomi non indica che tutti i patogeni siano stati eliminati. I germi rimanenti possono infatti causare una nuova insorgenza della malattia. È pertanto importante attenersi alle prescrizioni del medico e del farmacista.
L’impiego di antibiotici non dipende dalla gravità dell’infezione, bensì dal tipo di agente patogeno. I più frequenti sono batteri e virus. Raffreddore e influenza sono causati dai virus, il che rende gli antibiotici inefficaci.
L’osservanza della durata del trattamento e del dosaggio minimo è indispensabile per uccidere i batteri anche dopo la scomparsa dei sintomi iniziali ed è quindi importante proseguire la cura secondo le prescrizioni mediche. Solo in questo modo si evita che la terapia fallisca e che si sviluppi una resistenza.
Si parla di resistenza agli antibiotici quando i batteri sviluppano la capacità di contrastare l’efficacia dei farmaci utilizzati contro di loro. Gli agenti patogeni, anziché essere uccisi, si moltiplicano e le infezioni generate dai germi antibioticoresistenti risultano difficili o impossibili da trattare.
Secondo l’Organizzazione mondiale della sanità, le resistenze agli antibiotici provocano un aumento dei costi della salute, degenze ospedaliere prolungate e una maggiore mortalità. Entro pochi anni pochi anni alcuni degli antibiotici attualmente disponibili non saranno più efficaci.
L’uso eccessivo e inappropriato di antibiotici contribuisce allo sviluppo della resistenza agli stessi. Le nuove raccomandazioni degli esperti mirano a ridurre il più possibile l’uso di antibiotici.
Gli antibiotici di nuova concezione, efficaci contro gli agenti patogeni multiresistenti, sono generalmente riservati al settore ospedaliero per limitarne l’accesso. In questo modo si vuole evitare che l’uso sconsiderato di antibiotici da parte dei medici di base incentivi lo sviluppo di nuove resistenze.